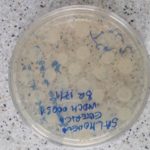

Основна дјелатност Лабораторије укључује одређивање остатака забрањених материја, ветеринарских лијекова и контаминаната у производима животињског поријекла намијењених за исхрану људи, узорцима животињског поријекла, житарица и хране за животиње, као и припрема микробиолошких подлога за потребе лабораторија Института.
Од остатака ветеринарских лијекова, анализе обухватају испитивања на присуство хлорамфеникола, флорфеникола, кленбутерола. Контаминанти чије присуство испитујемо су микотоксини, афлатоксин Б1, деоксиваленон, зеараленон, охратоксин А, фумонизин и Т2 токсин у храни за животиње, житарицама, сувом воћу и орашастим плодовима, као и афлатоксин М1 у млијеку, јогурту, сиру и другим млијечним производима. Поред ових, у Лабораторији се анализира риба и производи од рибе на присуство хистамина. Такође, корисницима нудимо и услугу утврђивања протеина меса различитих животињских врста.
Својим акредитованим методама Лабораторија знатно учествује у провођењу плана праћења резидуа и на тај начин наметнула се као једна од водећих лабораторија у овој области. Такође, лабораторија својим анализама спроводи мониторинге за потребе Министарства пољопривреде, шумарства и водопривреде Републике Српске.
Резултати и рад Лабораторије редовно се провјеравају кроз учешће у PT/ILC шемама организованим од стране свјетских и европских PT провајдера. Особље Лабораторије уз континуирану едукацију и рад са свјетски познатим експертима из ове области, као аутори или коаутори, објављују радове у научним и стручним часописима и узимају активно учешће на стручним и научним скуповима.
Поред имуноензимских испитивања, у Лабораторији се припремају микробиолошке подлоге и врши стерилизација прибора и опреме за потребе Института. У ту сврху користи се преко 150 различитих врста микробиолошких подлога, од којих се годишње направи око 8.500 литара готових микробиолошких подлога. Такође, у току године у Лабораторији се за потребе Института разлије око 100.000 петријевих плоча са микробиолошким подлогама. Лабораторија посједује и 50 различитих референтних сојева микроорганизама, чијом употребом редовно контролише исправност направљених микробиолошких подлога.
Особље Лабораторије:
Руководилац лабораторије: др Слободан Дојчиновић, доктор ветеринарске медицине-специјалиста (link: CV, библиографија, e-mail)
Стручни сарадник: мр Саша Ловрић, дипломирани инжењер пољопривреде (link: CV, библиографија, e-mail)
Испитивач: Слободанка Црнадак, санитарни инжењер
Испитивач: Дијана Милуновић, санитарни инжењер
Лаборант за припрему подлога: Неда Сикирић, ССС
Лаборант за прање и стерилизацију: Драгана Палачковић